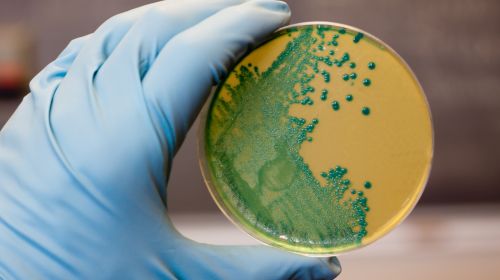

Abrir en el navegador
Abrir en el navegador
|

|

|
Noticias destacadas
|

|
España fija objetivos clave para liderar la investigación biomédica en 2025
El Comité de Coordinación de la Plataforma Tecnológica Española de Medicamentos Innovadores (PTEMI), compuesto...
Continuar leyendo
|
|

|
AseBio Te cuenta
|

|
AseBio traslada al Ministerio de Sanidad sus propuestas al futuro RD de Precio y Financiación de Medicamentos
El pasado 12 de diciembre de 2024 el Ministerio de Sanidad puso en marcha un proceso de consulta pública previa para...
Continuar leyendo
|
|

|

|
El EIC identifica a la biotecnología por su potencial para contribuir a la competitividad europea
El Consejo Europeo de Innovación (EIC, por sus siglas en inglés) ha publicado su "2024 EIC Tech Report",...
Continuar leyendo
|
|

|
Bioga Comunica
|

|
Bioga premia el trabajo de Biostatech, el proyecto ACE y DIVERSA Technologies en los XI Premios Bioga
El Clúster Tecnolóxico Empresarial das Ciencias da Vida de Galicia (Bioga), con el respaldo de la Xunta, a través de...
Continuar leyendo
|
|

|
Actualidad de Farmabiotec
|

|
Un nuevo tratamiento experimental muestra resultados prometedores contra el cáncer de mama más agresivo
Un equipo internacional de investigadores, liderado por el Instituto de Química Avanzada de Cataluña (IQAC-CSIC), ha desarrollado...
Continuar leyendo
|
|

|

|
Expertos analizan en Madrid el avance de la medicina de precisión en España
La Jornada ‘Precisión y Personalización: La Nueva Era de la Medicina’, organizada por MSD con la colaboración...
Continuar leyendo
|
|

|
MSD impulsa la medicina de precisión con expertos en la jornada ‘Precisión y Personalización: La Nueva Era de la Medicina’.
MSD, con la colaboración de la Sociedad Española de Anatomía Patológica (SEAP) y la Sociedad Española...
Continuar leyendo
|
|

|

|
La EMA acepta la revisión de la nueva jeringa precargada de Shingrix, la vacuna de GSK contra el herpes zóster
GSK plc ha anunciado que la Agencia Europea de Medicamentos (EMA) ha aceptado para revisión la solicitud regulatoria de una nueva...
Continuar leyendo
|
|

|
Oryzon Genomics propone una renovación estratégica en su Consejo de Administración
Oryzon Genomics S.A. ha anunciado importantes cambios en su Consejo de Administración, que serán propuestos durante la...
Continuar leyendo
|
|

|

|
Sermes CRO certificada bajo estándares internacionales ISO
Sermes CRO, organización de investigación por contrato (CRO) con 28 años de experiencia en el sector, ha anunciado...
Continuar leyendo
|
|

|
Zendal distribuye 42 millones de dosis de vacuna contra la lengua azul en Europa
Zendal cerró 2024 con la entrega de 42 millones de dosis de vacuna contra la lengua azul en sus distintas variantes (serotipos 3,...
Continuar leyendo
|
|

|

|
Touchlight se convierte en el primer fabricante de ADN sintético con certificación GMP para API
Touchlight CDMO ha anunciado que su planta en Hampton, Reino Unido, ha recibido la certificación GMP, convirtiéndose en el...
Continuar leyendo
|
|

|
IQS impulsa la nanomedicina con avances en vacunas de ARNm dirigidas al sistema inmunitario
El Dr. Nil González ha presentado en IQS su tesis doctoral, un avance significativo en el diseño de glicovacunas y la inmunoterapia...
Continuar leyendo
|
|

|

|
Kern Pharma apoya la investigación del IRB Barcelona contra el cáncer
Kern Pharma, laboratorio farmacéutico con sede en Terrassa (Barcelona), ha donado 4.120 euros al Instituto de Investigación...
Continuar leyendo
|
|

|
Crece la preocupación por el virus H5N1 en Estados Unidos: científicos aceleran el desarrollo de vacunas basadas en ARNm
Con el aumento de casos de gripe aviar A (H5N1) en el ganado y los humanos en Estados Unidos, científicos y autoridades sanitarias...
Continuar leyendo
|
|

|

|
Investigadores del CSIC desarrollan un método innovador para combatir la Listeria monocytogenes
Listeria monocytogenes, uno de los patógenos alimentarios más peligrosos, podría tener los días contados gracias...
Continuar leyendo
|
|

|

|
Artículos
|

|
Innovación y transformación digital: La evolución de la historia clínica digital
En la actualidad, la migración de las historias clínicas a la nube se ha convertido en un hito crucial en la evolución de la gestión...
Artículo completo
|
|

|

|
Tipos de isotermas y mecanismos de adsorción de disolventes en excipientes farmacéuticos
La interacción de los disolventes orgánicos y el agua con los polvos farmacéuticos es muy importante para comprender los procesos basados...
Artículo completo
|
|

|
Surfactante pulmonar: un medicamento huérfano capaz de salvarle la vida a los recién nacidos
Un viernes de madrugada, Eva (nombre ficticio) sintió que algo no iba bien con su bebé, así que se fue corriendo al hospital y, menos de...
Artículo completo
|
|

|
Cómo gestionar la contaminación por nitrosaminas en los ingredientes farmacéuticos activos
En 2018, la detección de nitrosaminas en fármacos del tipo sartán, medicamentos para tratar la hipertensión y la insuficiencia cardíaca,...
Artículo completo
|
|

|

|
Eventos recomendados
|

|
Medicalforum
20/05/2025
Tlf. +34 91 630 85 91 / +34 672 050 625 - Mail comercial@medicalforum.es, Barcelona (España)
Más información
|
|

|

|
Farmaforum 2025
17/09/2025
IFEMA, Pabellón 9, Madrid (España)
Más información
|
|
Empresas premium
|

|
|
Este mensaje y sus adjuntos contienen información confidencial y reservada dirigida exclusivamente a su destinatario. Si ha recibido este mensaje por error, se ruega lo notifique inmediatamente por esta misma vía y borre el mensaje de su sistema. Nótese que el correo electrónico vía Internet no permite asegurar ni la confidencialidad de los mensajes que se transmiten ni la correcta recepción de los mismos. Los datos derivados de su correspondencia se incluyen en un fichero de titularidad de OMNIMEDIA, S.L. cuya finalidad exclusiva es gestionar las comunicaciones de la empresa entendiéndose que usted consiente el tratamiento de los mismos con dicha finalidad al mantener tal correspondencia. El ejercicio de sus derechos de acceso, rectificación, cancelación u oposición puede realizarlo dirigiéndose por escrito a la dirección C/ Pollensa, 2, Edif. Artemisa of. 12 de LA ROZAS (28290 - MADRID) adjuntando una fotocopia de su NIF o documento identificativo.
Este mensaje se ha enviado a {{ campaign.sender.email }} que está registrado dentro del listado de suscriptores de nuestra revista. Si no desea recibir más información y darse de baja de nuestros boletines click aquí
|